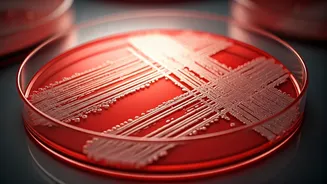
Summer's Secret Bloom: Unmasking Bacteria's Favorite Hotspots and How to Stay Safe

Unspoken Emotional Languages
Online content often surfaces that resonates deeply, not due to drama, but its stark authenticity. In one such instance, a 4-year-old boy, when asked about
his playtime preferences, expressed a profound sense of loneliness with a weary tone, stating he was always bored and that no one played with him. This poignant clip originated from a Korean reality television series featuring licensed therapists. The show's format focused on open discussions about parental behaviors and their emotional effects on children, offering guidance for relationship repair. The intention behind presenting such moments was not to induce judgment, but rather to foster awareness, accountability, and healing. While adults may be quick to dismiss such pronouncements as mere childishness, children internalize far more than just words; they register tone, perceived distance, and the overall emotional warmth of their environment. Crucially, they remember whether they felt genuinely included and accommodated.
The Weight of Sadness
The profound sadness expressed by the child in question stems from more than just a feeling of being alone. It highlights a child's acute awareness of their surrounding emotional climate. When questioned about his father, the boy described him as frightening when angry and wished for him to respond kindly. His assessment of his mother, however, was more definitive: 'I don’t think she loves me.' This statement is particularly gut-wrenching because a 4-year-old should not have to decipher affection, safety, or care through guesswork. Children should not be required to constantly monitor moods like they're predicting the weather, nor should they question whether love is conditional based on adult stress, irritation, or preoccupation. Many children, however, learn to construct theories from silences and map their emotional landscape based on the subtlest of indicators. They quickly become adept at 'reading the room' and, in turn, interpreting their own worth through that lens. When a child states 'She doesn’t listen,' it's not simply a complaint; it's a quiet testament to their experience of emotional isolation.
Absorbing Feelings Early
Even before they possess the linguistic tools to articulate their experiences, children are remarkably attuned to emotional cues. They diligently gather information from the velocity of a voice, the stiffening of a parent's face, the absence of a comforting hug, or words that are easily dismissed. Over time, these isolated incidents coalesce into deeply ingrained beliefs about themselves, such as 'I am a burden,' 'I am too much,' 'I am not worth appeasing,' or 'No one hears me when I speak.' These formative beliefs, often established within the family unit, can cast long shadows for years. The boy's tears are significant because they represent genuine emotion, not a performance. After a brief pause, he voiced a simple yet profound hope: that his mother would also play with him. This wasn't a demand or an act of defiance, but the most basic human desire: to be included and to feel wanted.
Beyond Basic Provision
It is crucial to recognize that many parents are not intentionally malicious; rather, they often find themselves overwhelmed, exhausted, and stretched thin, sometimes burdened by their own unaddressed emotional histories. This context is significant, as it helps explain how emotional neglect can occur subtly, often without the parent even realizing it. While this doesn't excuse the impact on the child, it sheds light on the circumstances. A parent might diligently provide food, shelter, and education, fulfilling the child's physical needs, yet inadvertently overlook the silent emotional void that is quietly growing. Children don't expect perfection from adults; what they truly require is the capacity for repair and reconnection. They need parents who can show kindness after moments of frustration, who can re-establish connection after withdrawal, and who are sensitive to the nuanced shifts in a child's demeanor, especially when they fall silent. Often, the most lasting harm isn't from a single outburst, but from the lack of subsequent reassurance and mending. The tone of communication is paramount; a harsh word can linger long after a conversation ends, while a warm reply can prevent a child from forming damaging conclusions about themselves.
Resonance of the Scene
This particular scene captivates viewers because it dismantles the comfortable notion that childhood distress always manifests loudly. Sometimes, it's the quiet image of a lonely child expressing their boredom and lack of playmates. At other times, it's the internal conviction of a child that love is unreliable. And then, there's the simple, four-word sentence that can leave an indelible mark on an adult listener: 'I think my mom doesn’t love me.' No child should ever have to voice such a sentiment publicly. The profound resonance of this moment across social media platforms underscores its impact; it transcends mere heartbreak, serving as a vital reminder of our responsibilities. We must cultivate more attentive listening and respond with greater empathy, moving past the tendency to view a child's emotional expressions as mere inconveniences. For young children, the manner in which parents communicate can shape their lifelong perspective. Even the smallest gestures of focused attention can serve as the foundational evidence that they are loved deeply and unconditionally.